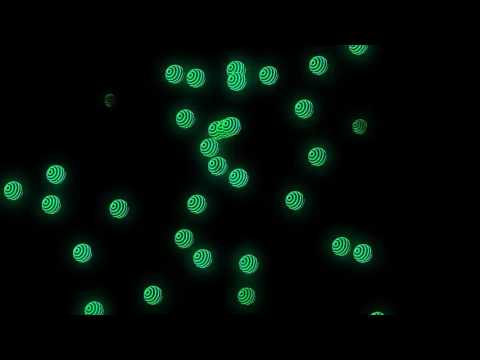
YouTube video

DOGE
89 posts


DOGE
@Dogedesigner
Sou um bosta esse é meu xanal :https://t.co/xXHsVRfuKl
Sobradinho-BA Katılım Ocak 2016
59 Takip Edilen104 Takipçiler

@PELUCIAAAAAAAAA @YouTube eu tava ligado nisso ae só q n tão perfeito
Português


Estou jogando My Singing Monsters. Experimente! play.google.com/store/apps/det…
Português

@rezende_evil money money money money crianças entretenimento pra ele ganha oq alimento e dinheiro
Português